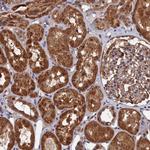
PDE12 Antibody in Immunohistochemistry (Paraffin) (IHC (P))

Search
Invitrogen
PDE12 Polyclonal Antibody
{{$productOrderCtrl.translations['antibody.pdp.commerceCard.promotion.promotions']}}
{{$productOrderCtrl.translations['antibody.pdp.commerceCard.promotion.viewpromo']}}
{{$productOrderCtrl.translations['antibody.pdp.commerceCard.promotion.promocode']}}: {{promo.promoCode}} {{promo.promoTitle}} {{promo.promoDescription}}. {{$productOrderCtrl.translations['antibody.pdp.commerceCard.promotion.learnmore']}}
产品信息
PA5-60267
种属反应
宿主/亚型
分类
类型
抗原
偶联物
形式
浓度
规格
纯化类型
保存液
内含物
保存条件
运输条件
RRID
产品详细信息
Immunogen sequence: CGDFNSTPST GMYHFVINGS IPEDHEDWAS NGEEERCNMS LTHFFKLKSA CGEPAYTNYV GGFHGCLDYI FIDLNALEVE QVIPLPSHEE VTT
Highest antigen sequence identity to the following orthologs: Mouse - 92%, Rat - 97%.
靶标信息
PDE12 is an enzyme that cleaves 2',5'-phosphodiester bond linking adenosines of the 5'-triphosphorylated oligoadenylates, triphosphorylated oligoadenylates referred as 2-5A modulates the 2-5A system. This enzyme degraded triphosphorylated 2-5A to produce AMP and ATP. It also cleaves 3',5'-phosphodiester bond of oligoadenylates and plays a role as a negative regulator of the 2-5A system that is one of the major pathways for antiviral and antitumor functions induced by interferons (IFNs). Suppression of this enzyme induces reduction of viral replication in Hela cells, thus counteracting the antiviral pathway probably by inhibiting the 2-5A system.
仅用于科研。不用于诊断过程。未经明确授权不得转售。
篇参考文献 (0)
生物信息学
蛋白别名: 2',5'-phosphodiesterase 12; 2'-PDE; 2'-phosphodiesterase; Mitochondrial deadenylase; unnamed protein product
基因别名: 2'-PDE; 2-PDE; PDE12
UniProt ID: (Human) Q6L8Q7
Entrez Gene ID: (Human) 201626